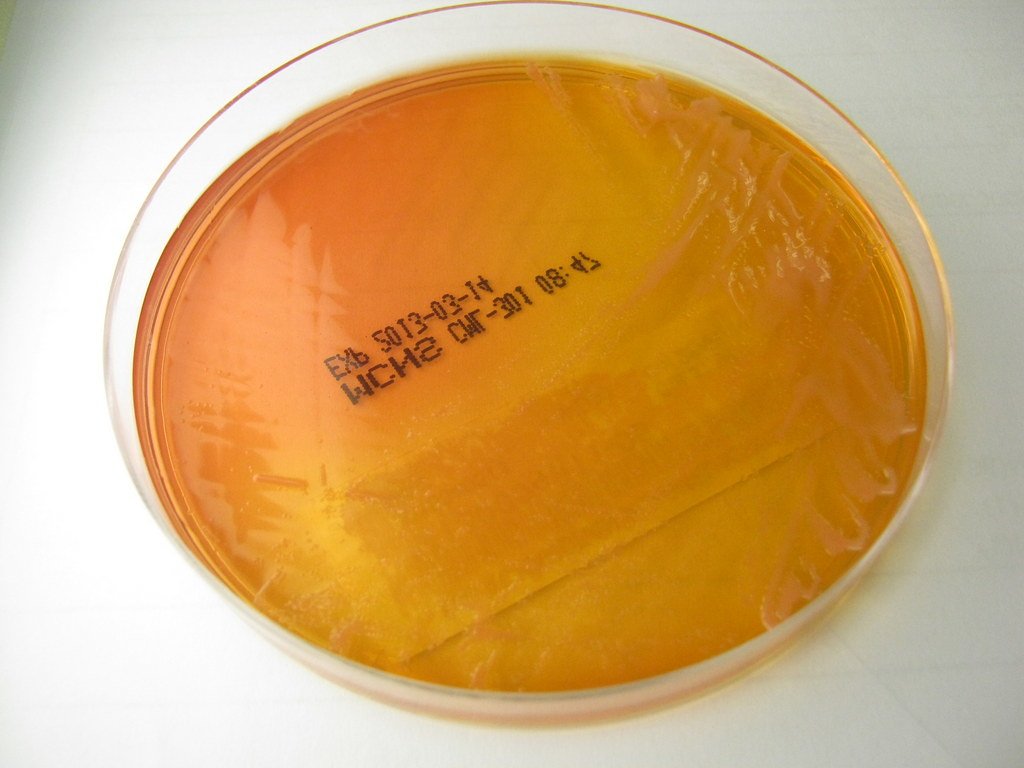
Rhizobium radiobacter

Earth is a bustling planet powered by a remarkable array of microorganisms that play key roles in sustaining life. Though invisible to the naked eye, these tiny but mighty beings are indispensable in driving essential processes, from soil fertility to the air we breathe. Let’s delve into the fascinating world of microorganisms, which, despite their microscopic size, have a monumental impact on our planet.
1. Nitrogen-Fixing Bacteria: Nature’s Fertilizer Factories
These bacteria, including species such as Rhizobium, play a critical role in transforming atmospheric nitrogen into a form that plants can use for growth. Found in soil and plant roots, nitrogen-fixing bacteria live symbiotically with leguminous plants, enhancing soil fertility and reducing the need for chemical fertilizers.
2. Cyanobacteria: Pioneers of Photosynthesis

Cyanobacteria are among Earth’s oldest life forms, crucial for producing oxygen through photosynthesis. These microorganisms were vital in forming the atmosphere as we know it today, enabling other life forms to evolve and thrive.
3. Methanogens: Nature’s Clean Energy Producers

Found in anaerobic environments like wetlands and the guts of ruminants, methanogens produce methane, a potential renewable energy source. Their role in carbon cycling makes them essential contributors to energy dynamics and our understanding of global warming.
4. Lactobacillus: Guardians of Gut Health

Lactobacillus species are lauded for their beneficial effects on human and animal digestive systems. Known as probiotics, these bacteria help maintain gut flora balance, boost immunity, and even aid in the digestion of lactose, making them invaluable to health and wellness.
5. Thermophiles: Extremists of the Microbial World

Living in hot environments, such as geothermal springs and hydrothermal vents, thermophiles not only survive but thrive in extreme conditions. They offer insights into the adaptability of life and have applications in industrial processes, including the development of heat-stable enzymes.
6. Archaea: Ancient Earth Inhabitants

Archaea are unique microorganisms similar in appearance to bacteria but distinct genetically and biochemically. They occupy diverse habitats, from oceanic depths to extreme environments. Their ability to metabolize different forms of energy makes them crucial in nutrient cycles.
7. Decomposers: Nature’s Recyclers

Microorganisms like fungi and certain bacteria decompose organic matter, returning essential nutrients to the soil. This decomposition is vital for soil fertility, enabling plant growth and maintaining ecosystem health.
8. Plankton: Base of the Food Web

Though not always visible, phytoplankton and zooplankton serve as the foundational food source for marine ecosystems. Phytoplankton, in particular, contribute to oxygen production, rivaling terrestrial plants in their output.
9. Mycorrhizal Fungi: Plant Allies

These fungi form symbiotic relationships with plant roots, enhancing nutrient uptake, improving plant health, and helping ecosystems withstand environmental stressors. Their networks also facilitate communication between plants.
10. Escherichia coli: A Misunderstood Microbe

While often linked to foodborne illness, E. coli strains are pivotal in biotechnology and research, aiding in genetic studies and antibiotic production. They inhabit the intestines of warm-blooded organisms, contributing to gut health.
11. Algae: More Than Meets the Eye

Present in diverse environments, algae are vital for carbon fixation and form the base of numerous aquatic food chains. Their ability to produce biofuels positions them as potential sustainable energy sources.
12. Halophiles: Salt-Tolerant Survivors

Thriving in high-salinity environments like salt flats, halophiles have unique metabolic pathways that provide insights into cellular adaptation and biotechnological applications, such as saline wastewater treatment.
13. Yeasts: Fermentation Powerhouses

Yeasts are indispensable to the food and beverage industry, from bread-making to brewing. Saccharomyces cerevisiae, for instance, is instrumental in ethanol production and has become a model organism in cell biology research.
In conclusion, these remarkable microorganisms, in myriad ways, contribute to the intricate web of life on Earth. Whether by cycling nutrients, fueling industries, or advancing scientific knowledge, their impact on both natural ecosystems and human civilization is profound and far-reaching. Understanding and appreciating the roles these microorganisms play underscores the importance of biodiversity and conservation efforts crucial for maintaining the balance of life on our planet.




